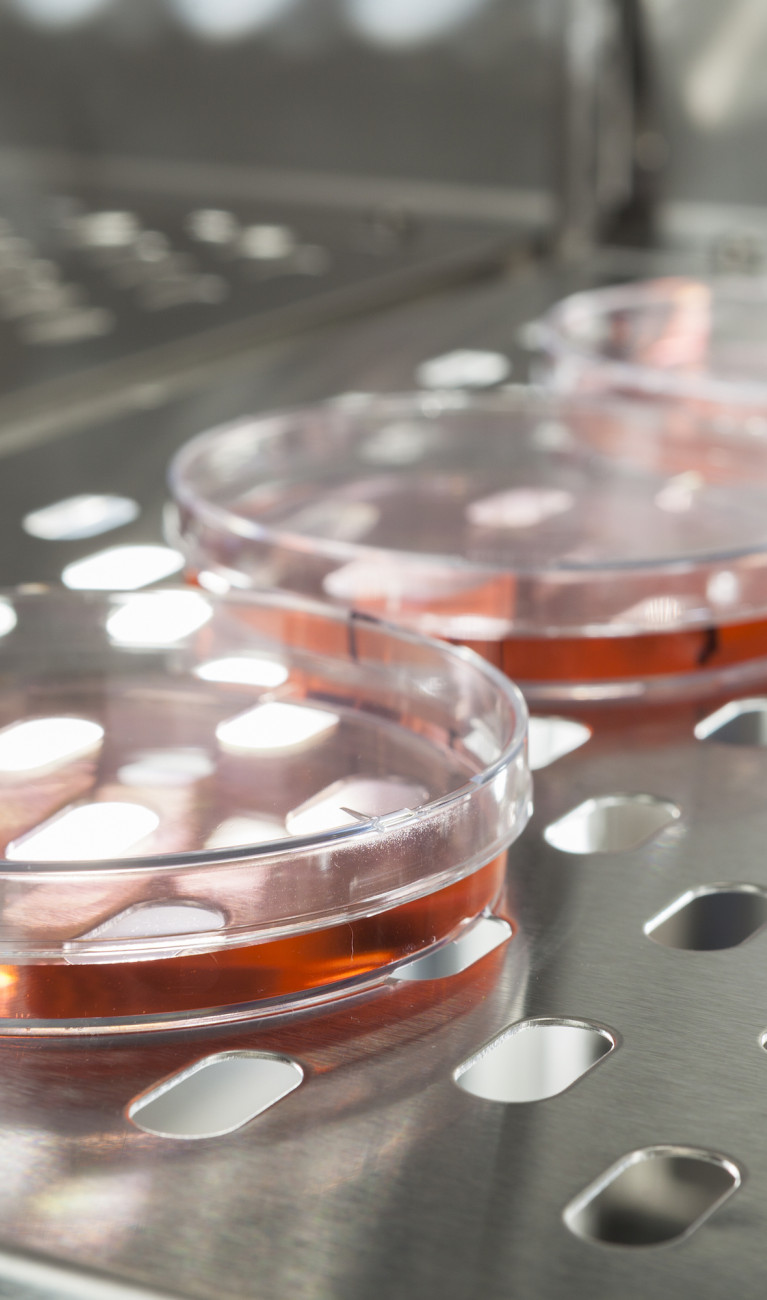
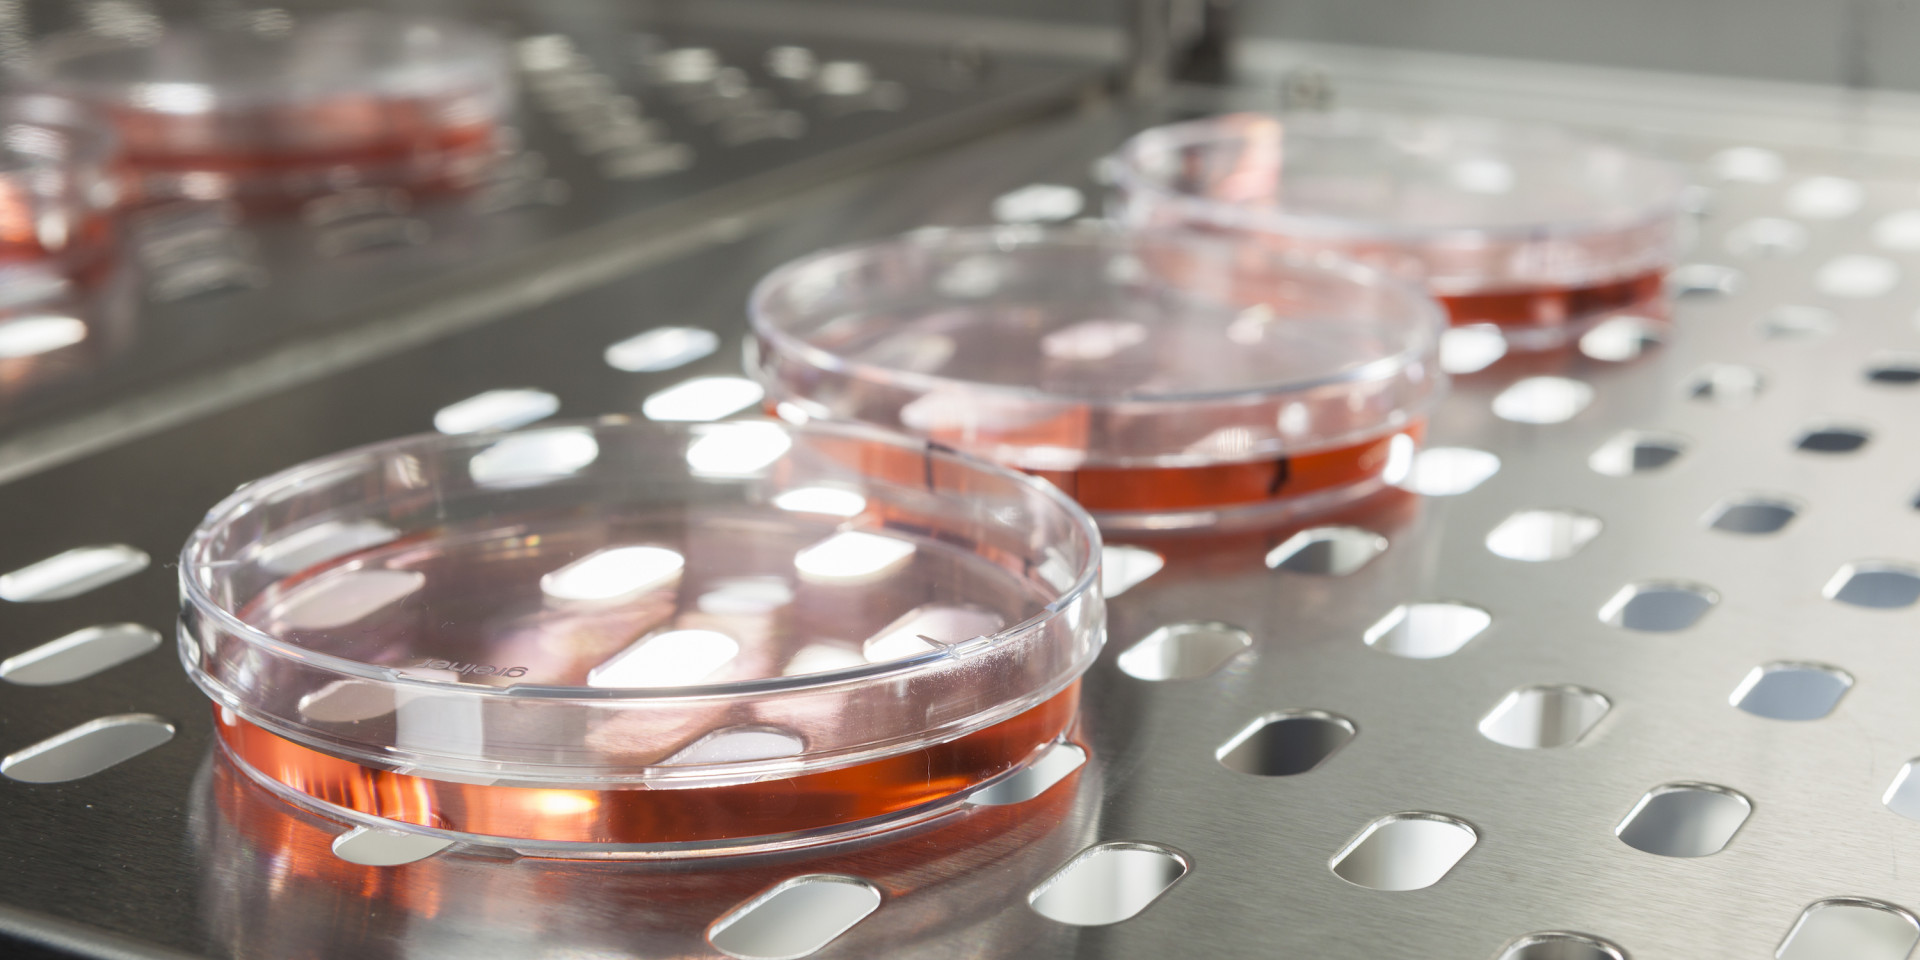

Ziel des Projektes „Cross-Over - Übergänge im Lebenslangen Lernen" ist die Entwicklung von Strukturen zur Verbesserung der Durchlässigkeit zwischen akademischer und beruflicher Bildung im Bereich Biotechnologie/Biopharmazie/Medizintechnik.
Das Projekt beinhaltet die Entwicklung und Implementierung von maßgeschneiderten Studienangeboten an der fachlichen Schnittstelle zwischen Biotechnologie/ Biopharmazie/Medizintechnik. Diese sollen Anknüpfungspunkte an unterschiedliche Stufen der beruflichen Praxis und der fachwissenschaftlichen Qualifikation schaffen, und somit individuell auf unterschiedliche Ausgangsvoraussetzungen zugeschnitten sein.
Das Angebotsspektrum reicht dabei von niederschwelligen Brückenkursen, über Kontaktstudienangebote und Zertifikatsmodule auf Bachelor- und Masterniveau bis hin zu dem berufsbegleitenden Master Biopharmazeutische-Medizintechnische Wissenschaften (M.Sc.).
Laufzeit:
2016-2020
Assoziierter Partner:
Duale Hochschule Baden-Württemberg / Heidenheim
Projektunterstützer:
Boehringer Ingelheim, Rentschler, Verband forschender Arzneimittelhersteller
Mittelgeber:
Ministerium für Wissenschaft, Forschung und Kunst Baden-Württemberg, Europäischer Sozialfond
Kooperationspartner:
Förderprogramm:
"Auf- und Ausbau von Strukturen der wissenschaftlichen Weiterbildung an Hochschulen in Baden-Württemberg".